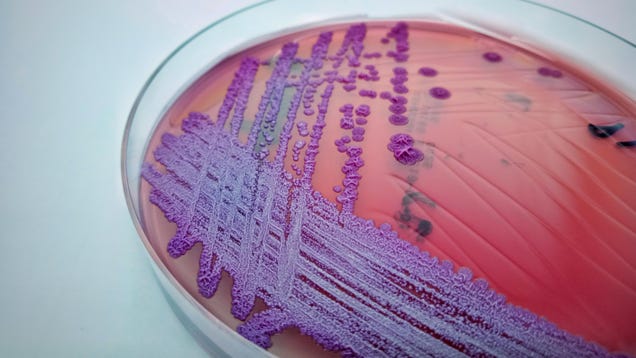

A bacteria endemic to tropical areas that causes life-threatening infection has just been detected within the soil and waters of the continental U.S. for the first time. On Wednesday, the Centers for Disease Control and Prevention reported that they recently isolated Burkholderia pseudomallei bacteria in southern…
Source: Gizmodo – A Deadly Tropical Bacteria Has Been Found in Continental U.S. Soil for the First Time
